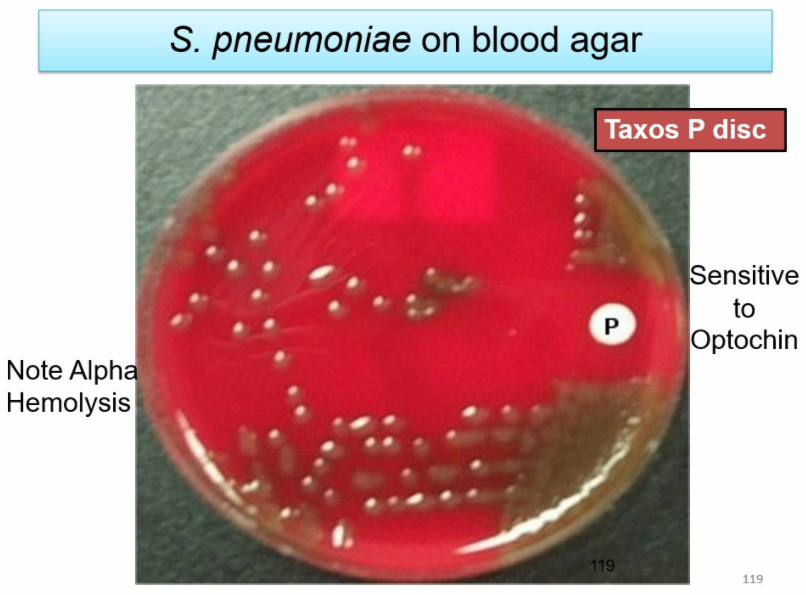
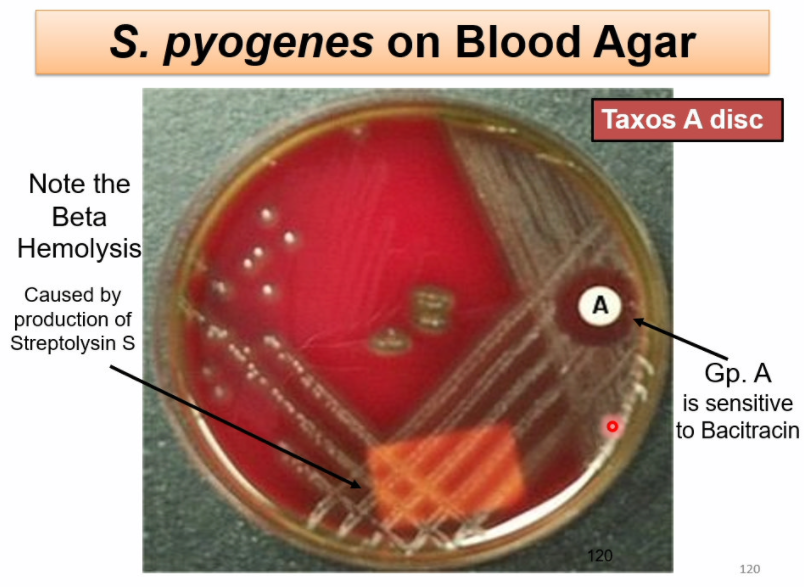

summarize community-acquired pneumonia and hospital-acquired pneumonia

list common typical causes of CAP
- Streptococcus pneumoniae
- H. influenzae
- Klebsiella
- Staph aureus

name clinical features associated with typical CAP
- usually one lobe involved
- acute onset, increased fever, pleuritic chest pain, productive cough
- signs of consolidation:
- dullness
- vocal fremitus/resonance
- egophony
- whispered pectoriloquy
- bronchial breath sounds
- Dx = CXR

describe the appearance of S. pneumoniae on blood agar
describe the appearance of S. pyogenes on blood agar
_____ is the commonest cause of community-acquired pneumonia
S. pneumoniae is the commonest cause of community-acquired pneumonia

describe the pathogenesis of Pneumococcal pneumonia
- capsule
- IgA protease
- pneumolysin
- autolysin
- transformation
describe properties of pneumolysin

describe the sputum seen in S. pneumoniae infection
rusty colored (reddish-brown)
describe prevention of Pneumococcal pneumonia and the high risk populations it is indicated for
- “polyvalent” capsular polysaccharide vaccine
- immunizes against 23 of the most common serotypes
- high risk individuals:
- age >65
- chronic disease
- HIV
- alcoholism
- splenectomy patients
Klebsiella is a (G+ve/G-ve) ____ (shape)
Klebsiella is a G-ve bacillus

Klebsiella has a large ____, which gives it a mucoid appearance
Klebsiella has a large polysaccharide capsule, which gives it a mucoid appearance

Klebsiella causes ____ of lung tissue, due in part to response to _____
Klebsiella causes necrotization of lung tissue, due in part to response to endotoxin (LPS)

name the at-risk individuals for Klebsiella infection
- CAP
- alcoholics
- diabetics
- COPD
- HAP
- ventilators
- IV catheters

describe the sputum seen in Klebsiella infection
“red currant jelly” sputum

in Klebsiella pneumoniae, 2 high affinity ___ uptake systems: _____& _____ helps in bacterial growth
in Klebsiella pneumoniae , 2 high-affinity iron uptake systems: aerobactin & enterochelin helps in bacterial growth
describe the role of the LPS in Klebsiella pneumoniae
- LPS (O antigen)
- prevents ingestion by phagocytes, detection of somatic antigens by host’s antibodies
- impedes complement (especially C3b); inhibits opsonization

Klebsiella pneumoniae produces ____ which gives it ____ resistance
Klebsiella pneumoniae produces carbapenemase which gives it carbapenem resistance

the ___ found in Klebsiella pneumoniae allows attachement to ____ and ____ formation
the pili (fimbriae) found in Klebsiella pneumoniae allows attachment to epithelium and biofilm formation

describe the spread of Klebsiella pneumoniae
exposure to bacteria required, person to person via contamination of hands or environment (NOT spread through air)

describe the Sketchy


Pseudomonas sp. is found in _____
Pseudomonas sp. is found in still fresh water sources

list the persons that are at highest risk for Pseduomnas infections
- particularly dangerous for persons with structural defects in body defenses:
- burn victims
- CF
- HAP

the most common infection caused by Pseudomonas sp. is _____
the most common infection caused by Pseudomonas sp. is otitis externa aka swimmer’s ear

















